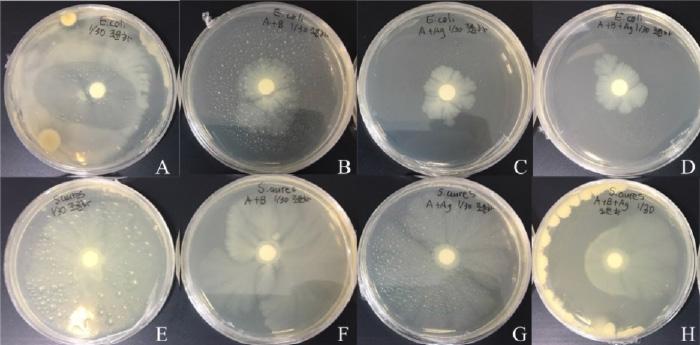

14 minute read
Investigating the Effectiveness of Bacteriocin and SIlver Nanoparticles Yunha Jo
from JOURNYS Issue 12.1
by JOURNYS
By: Yunha Jo || Art By: Jessie Gan
Advertisement
Abstract
With food waste as one of the major issues faced by the world, many countries are looking to develop different methods to reduce the waste. One of the possible methods is the use of bacteriocin, ribosomally-synthesized bacterial antimicrobial peptides produced by bacteria and silver nanoparticles, which are known to enhance antibacterial activities. The objective of this research was to test the effectiveness of bacteriocin produced from l.sakei combined with silver nanoparticles produced from Traditional Chinese Medicine (TCM). The effectiveness of bacteriocin and silver nanoparticles were tested against Escherichida Coli and Staphylococcus aureus, major bacteria in causing food-borne diseases in humans.
Introduction
Food waste has been one of the major issues faced by countries around the world, with almost one-third of food produced being wasted [1]. The economic losses due to food waste amount to 1.3 billion USD, around 900 million dollars in environmental costs and 400 million dollars in social costs. [2] As a result of this loss, many countries are looking for ways to solve this issue. Some of the current approaches to solving the issue include extending shelf-life of food products. New types of food packaging such as edible coatings and modified atmosphere storage are used to extend the shelf life. [4] Another method would be to use bacteriocin.
Bacteriocins are ribosomally-synthesized bacterial antimicrobial peptides produced by bacteria. [5] They can kill or inhibit bacterial strains closely related or nonrelated. These characteristics of bacteriocins are effective for controlling bacterial growth in different medium, and as a result, bacteriocins are most often used as food preservatives, anti-biofilm agents, and additives or alternatives to existing antibiotics. [6] Bacteriocins are produced from lactic acid bacteria (LAB), which is a group that occurs naturally in food and have been used in dairy products safely. [7] This makes bacteriocin a great alternative to chemical preservatives. Bacteriocin can be produced from lactobacillus sakei, which can be found in kimchi, Korean fermented vegetables. [8]
The effectiveness of bacteriocins can be enhanced through the use of nanoparticles. Studies have shown that nanoparticles improve properties and antibacterial activities of bacteriocins. [9] Silver nanoparticles have proven to be especially effective in enhancing the antibacterial activities of bacteriocins. [9] Due to this, silver nanoparticles will be used in the experiment in order to investigate how the
effectiveness of bacteriocins change when silver nanoparticles are added. Silver nanoparticles can be synthesized from different methods, including physical, chemical, and biological methods. Traditional Chinese medicines (TCM) can be used in synthesis of silver nanoparticles and have been proven to have a potential role as antibacterial agents. [10] Silver nanoparticles synthesized from TCM will be used in the experiment.
The objective of this research is to test the effectiveness of bacteriocin produced from l.sakei combined with silver nanoparticles produced from TCM. In order to test this, Escherichida Coli (E. coli) and Staphylococcus aureus (S. aureus) were used, as they are major bacteria in causing foodborne diseases in humans. [11] As applications of the research, films that contained bacteriocin and nanoparticles were developed.
Preliminary Experiment and Results
In order to determine which substance was most effective for creating bacteriocin, a preliminary experiment was done. First, a culture medium was created using 11.5g of De Man, Rogosa and Sharpe (MRS) Agar and 35g of Nutrient Agar. MRS Agar and Nutrient Agar were then each dissolved in 500 mL of distilled water in separate flasks. The flasks were placed into the autoclave for 15 minutes at 121 degrees Celsius, then poured onto the Petri dishes and set to cool to create culture mediums.
Secondly, the lactobacillus was cultured. 100 μl of kimchi, yogurt, and probiotics liquid were extracted and put into Eppendorf tubes (microtubes). Then, 20 μl of each liquid were measured using a pipette then poured onto Petri dishes. Each of the liquid was streaked using loops, sealed, then put into an incubator to cultivate lactobacillus. After a couple of days, the Petri dishes were taken out of the incubator and examined for the appearance of lactobacillus. As kimchi exhibited the most growth, kimchi lactobacillus was utilized to test for effectiveness against bacteria.
Cultivated kimchi lactobacillus was scraped off using a loop then put into a microtube containing 100 μl MRS broth. The optical density for the mixture was then measured. The microtube was placed into a centrifuge to separate bacteriocin from the liquid. After the centrifuge, the mixture was filtered using a supernatant filter. 20 μl of S. Aureus and E. Coli were measured, poured onto two Petri dishes, then spread across the dishes to create bacterial lawns. Dispense discs were then placed on each dish and 10 μl of filtered lactobacillus were poured onto the discs. The dishes were then placed in an incubator at 37°C and observed for a few days. After a few days, the dishes yielded no significant results.
In order to create effective bacteriocin, 100 μl of kimchi, yogurt, and probiotics were poured into the microtube along with MRS broth. The microtubes were then placed into an incubator. After a few days, the liquids in microtubes were taken out, filtered, and tested for effectiveness against E. Coli and S. Aureus using the same methods described above. The clear zone was observed for kimchi lactobacillus against E.Coli bacterial colonies.
These results indicated that kimchi lactobacillus was the most effective in creating bacteriocin, so in the following experiments, kimchi lactobacillus and L.sakei were used. Bacteriocins were created from lactobacillus grown from L.sakei. Lactobacillus was dissolved in distilled water, centrifuged, then filtered in order to get bacteriocin.
Procedures and Results Part 1: Bacteriocin and Silver Nanoparticles Produced from TCM Extract 50 grams of TCM waste and 200 mL of distilled water were mixed in a 2-liter Erlenmeyer flask then placed into Autoclave for 80 minutes. The mixture was then put into a centrifuge, then the supernatant was put into microtubes.
Next, the effectiveness of bacteriocin produced from TCM extract was determined. In the first microtubes, 1 mL of TCM extract and 20 μl of lactobacillus were mixed. 1 mL of TCM extract was put into another microtube to act as a control group. In the third Eppendorf tube, 1 mL of MRSB and 20 μl of lactobacillus was mixed. 1 mL of MRSB was put into a microtube to act as the control. In the final microtube, 500 μl of TCM extract and 500 μl of AgNO3 were placed. All five microtubes were placed into an incubator and left for three days. After three days, the microtubes were taken out and their optical densities were measured.
Table 1: Comparing Optical Densities of MRSB-grown bacteriocin and TCM Extract-grown bacteriocin

Figure 1: Mixture of 500 μl of TCM and 500 μl of AgNO3

As shown in the table, lactobacillus grown from TCM extract had a significantly low amount compared to lactobacillus grown from MRS B. On the other hand, it was shown that Silver nanoparticles can be produced from TCM extracts. Thus, TCM was chosen as the medium for cultivating silver nanoparticles and not bacteriocin.
In order to determine if bacteriocin and silver nanoparticles indeed had better effectiveness, a series of experiments was done. Agar and Pullulan were used to observe their characteristics and determine which one was most suitable for creating films in the end.
Six microtubes were prepared. In three microtubes, 1 mL of Pullulan was poured. In the other three, 1 mL of Agar was poured. In one microtube, 200 μl of Silver Nitrate was placed. In another microtube, 50 μl of bacteriocin were placed. In the final microtube, 200 μl of Silver Nitrate and 50 μl of bacteriocin was placed. These steps were repeated with three other microtubes, with the new microtubes containing 1 mL Agar instead of 1mL Pullulan. This way, the effects of bacteriocin, Silver Nanoparticles, and the combined effects could be observed, as well as the characteristics of Agar and Pullulan.
Two culture mediums were prepared. 20 μl of E.coli were then spread onto one medium and 20 μl of S.aureus on the other. Six disc papers were prepared. Two of the disc papers were dipped into microtubes containing Pullulan from above then each placed on a different culture medium. In the end, two culture mediums were produced, each with three disc papers each dipped in different solutions in the microtubes. These disc papers were then placed into incubators for three days and changes were observed.
For Agar, each of the disc papers was placed onto different culture mediums and bacterial growth was observed for each of the mediums.
Figure 2:
On left: Petri dish with E.Coli with Pullulan mixtures. On right: Petri dish with S.aureus with Pullulan mixtures Figure 3
Pictures of individual disc papers dipped in pullulan observed under a microscope. A) E.coli and bacteriocin. B) E.Coli and silver nanoparticles. C) E.coli with bacteriocin and silver nanoparticles D) S.aureus and bacteriocin. E) S.aureus and silver nanoparticles. F) S.aureus with bacteriocin and silver nanoparticles

Figure 4
Petri dishes spread with E.coli and S.aureus with discs dipped in AgarA) E.coli. B) E.coli with bacteriocin. C) E.Coli with silver nanoparticles. D) E.coli with silver nanoparticles and bacteriocin. E) S.aureus. F) S.aureus with bacteriocin. G) S.aureus with silver nanoparticles. H) S.aureus with silver nanoparticles and bacteriocin.
Notice that clear zones were observed around Silver nitrate and bacteriocin mixture in S.aureus and E.coli. This demonstrates that the effectiveness of bacteriocin indeed increases when mixed with silver nitrate. Furthermore, seeing that the clear zone around the paper disc dipped into bacteriocin and silver nitrate mixture was the biggest. With this, it can be concluded that the mixture is the most effective.
Differences between Pullulan and Agar were also observable. While Pullulan remained as a solution even after a long time, Agar quickly hardened after a little period of time. In addition, Pullulan melted when put
into water, while Agar absorbed water. Considering the nature of the investigation and possible applications as bio preservative films, it was decided that Pullulan would be better for creating films because Pullulan would be more effective in releasing Bacteriocin and Silver nanoparticles into food products.
Given that the effectiveness of Bacteriocin increases when silver nitrates are added, an investigation into whether bacteriocin and silver nitrates could both be cultivated from TCM waste. Silver nitrates can be produced from lactobacillus as well. This indicates that when lactobacillus and silver nitrates are both cultivated from the same medium, the growth of lactobacillus may decrease after a certain amount of time.
Eleven different test tubes were prepared. (From now on, these test tubes will be referred by their numbers)


Table 2: Test tubes and their contents
The test tubes were placed into an incubator and changes were observed after 7 days.
Next, the effectiveness of these mixtures in inhibiting bacterial growth was determined. On the first culture medium, E.coli was spread, then five disc papers each dipped in test tubes 2, 5, 8, 10, and 11 were placed. On the first culture medium, E.coli was spread, then five disc papers each dipped in test tubes 2, 5, 8, 10, and 11 were placed. On the second culture medium, E.coli was spread, then five disc papers each dipped in test tubes 3, 6, 9, 10, and 11 were placed. These steps were repeated with S.aureus in two more culture mediums. All four culture mediums were placed in an incubator for two days and the following changes were observed.

Figure 6 Petri dishes with Paper Discs dipped into the solutions A) E.Coli with solutions 2, 5, 8, 10, 11. B) S.aureus with 2, 5, 8, 10, 11. C) E.Coli with 3, 6, 9, 10, 11. D) S.aureus with 3, 6, 9, 10, 11

The results of the experiment showed that bacteriocin and silver nanoparticles had greater effectiveness in inhibiting bacterial growth. It also showed that 0.3 mL of silver nanoparticles was most effective.
Next, it was observed whether the effectiveness increased when bacteriocin and silver nanoparticles were cultivated using different methods.
First, 200 ul of bacteriocin from lactobacillus were prepared then mixed with 300 μl of Pullulan. 200 ul of TCMcultivated silver nanoparticles were mixed with 300 μl of Pullulan as well. Then, 100 μl of bacteriocin, 100 μl of silver nanoparticles, and 300 μl of Pullulan were mixed. Finally, 200 μl of the mixture from test 5 above were mixed with 300 μl of Pullulan. The four mixtures were placed into an oven for 30 minutes until they became films. These films were then placed onto four culture mediums with E.coli spread onto them. The changes were observed for the following days.
The results showed that bacteriocin and silver nanoparticles mixed together after cultivated differently have better effectiveness against bacteria.
Figure 5: Test Tubes 2, 3, 5, 6, 8, 9 (Note 1, 4, and 7 were taken out because silver nitrates were not added)
Figure 7: Films created from different mixtures
A) E.Coli with Bacteriocin. B) E.Coli with Silver Nanoparticles. C) E.Coli with B and Ag mixture. D) E.Coli with B and Ag cultivated from the same medium.

Discussion
Although bacteriocin and silver nanoparticles were not tested on food products, the experiment has yielded enough results to demonstrate that bacteriocins and silver nanoparticles will be effective in extending the shelf life of products. The films made using bacteriocins and silver nanoparticles could be used in extending the shelf-life of liquid products such as soup as they readily dissolve in water. Since bacteriocins are already being used in dairy products, the films can also be applied to those products.
The users of the films can also control the amount of silver nanoparticles and bacteriocin present in the films. The results of the research have demonstrated that the effectiveness of silver nanoparticles and bacteriocin differ based on how much are present, so the users can manipulate the amounts to obtain maximum efficacy. Different amounts can be used for different purposes across fields.
In addition to this, the dangers of silver nanoparticles have to be considered. The toxicity of silver nanoparticles have been researched thoroughly: once silver nanoparticles are transported to cellular and orgasmic levels, they can be quite deadly to humans. [12] This issue can possibly be solved by controlling the amounts of silver nanoparticles and bacteriocin that are put into the films. Creation of bacteriocin may hinder growth of silver nanoparticles, so by adding more bacteriocin to the films, it can minimize the possible dangers posed by silver nanoparticles.
Citations [1] Schanes, Karin, et al. “Food Waste Matters - A Systematic Review of Household Food Waste Practices and Their Policy Implications.” Journal of Cleaner Production, Elsevier, 8 Feb. 2018, www.sciencedirect.com/science/article/ pii/S0959652618303366. [2] “FAO.org.” Food Loss and Food Waste | Policy Support and Governance | Food and Agriculture Organization of the United Nations | Policy Support and Governance | Food and Agriculture Organization of the United Nations, www.fao. org/policy-support/policy-themes/ food-loss-food-waste/en/. [3] “What Governments, Farmers, Food Businesses – and You – Can Do about Food Waste.” FAO, www.fao.org/news/ story/en/item/196377/icode/. [4] Saini, Gaganpreey Kaur. “Extending the Shelf Life of Agricultural Products: Five Approaches for Success.” Global Food Safety Resource, 18 Aug. 2017, globalfoodsafetyresource. com/extending-the-shelf-life-of-agricultural-productsfive-approaches-for-success/. [5] Yang, Shih-Chun, et al. “Antibacterial Activities of Bacteriocins: Application in Foods and Pharmaceuticals.” Frontiers in Microbiology, Frontiers Media S.A., 26 May 2014, www.ncbi.nlm.nih.gov/pmc/articles/PMC4033612/. [6] Hammami, et al. “Editorial: Application of Protective Cultures and Bacteriocins for Food Biopreservation.” Frontiers, Frontiers, 21 June 2019, www.frontiersin.org/ articles/10.3389/ fmicb.2019.01561/full. [7] Silva, et al. “Application of Bacteriocins and Protective Cultures in Dairy Food Preservation.” Frontiers, Frontiers, 15 Mar. 2018, www.frontiersin.org/articles/10.3389/ fmicb.2018.00594/full. [8] Kwon, Min-Sung, et al. “Lactobacillus Sakei WIKIM30 Ameliorates Atopic Dermatitis-Like Skin Lesions by Inducing Regulatory T Cells and Altering Gut Microbiota Structure in Mice.” Frontiers in Immunology, Frontiers Media S.A., 14 Aug. 2018, www.ncbi.nlm.nih.gov/ pmc/ articles/PMC6102352/. [9] Fahim, Hazem A, et al. “Nanotechnology: A Valuable Strategy to Improve Bacteriocin Formulations.” Frontiers in Microbiology, Frontiers Media S.A., 16 Sept. 2016, www. ncbi.nlm.nih.gov/pmc/articles/PMC5026012/. [10] Sun, Wenjie, et al. “Enhanced Stability and Antibacterial Efficacy of a Traditional Chinese MedicineMediated Silver Nanoparticle Delivery System.” International Journal of Nanomedicine, Dove Medical Press, 26 Nov. 2014, www.ncbi.nlm.nih.gov/pmc/articles/
PMC4251751/. [11] Gutiérrez, Diana, et al. “Incidence of Staphylococcus Aureus and Analysis of Associated Bacterial Communities on Food Industry Surfaces.” Applied and Environmental Microbiology, American Society for Microbiology, 15 Dec. 2012, aem.asm.org/content/78/24/8547. [12] Stensberg, Matthew Charles, et al. “Toxicological Studies on Silver Nanoparticles: Challenges and Opportunities in Assessment, Monitoring and Imaging.” Nanomedicine (London, England), U.S. National Library of Medicine, July 2011, www.ncbi.nlm.nih.gov/pmc/articles/
PMC3359871/.